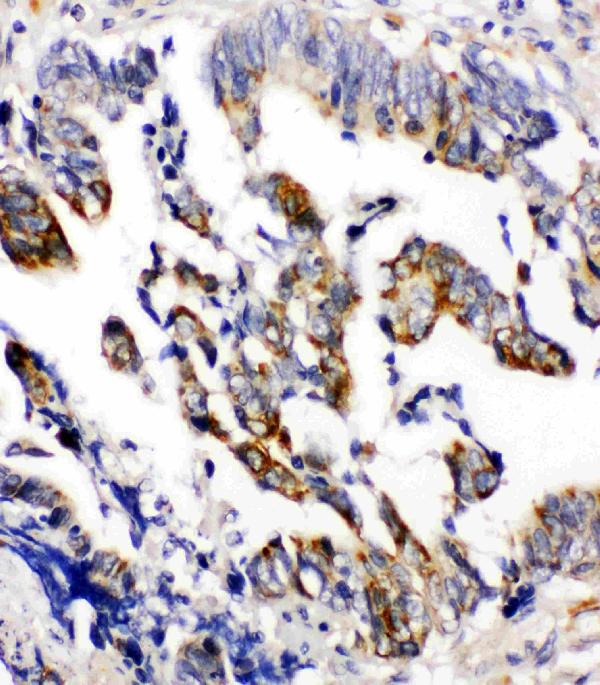
Anti-Beta Arrestin 2 antibody, PA1845, IHC(P) IHC(P): Human Intestinal Cancer Tissue

ARRB2 / Beta Arrestin 2 Antibody
LS-C814095
ApplicationsImmunoFluorescence, Western Blot
Product group Antibodies
TargetARRB2
Overview
- SupplierLifeSpan BioSciences
- Product NameARRB2 / Beta Arrestin 2 Antibody
- Delivery Days Customer23
- Application Supplier NoteApplications should be user optimized.
- ApplicationsImmunoFluorescence, Western Blot
- Applications SupplierIF (1:100 - 1:500), WB (1:1000 - 1:2000) Applications should be user optimized.
- CertificationResearch Use Only
- ClonalityMonoclonal
- ConjugateUnconjugated
- Estimated Purity...
- Gene ID409
- Target nameARRB2
- Target descriptionarrestin beta 2
- Target synonymsARB2, ARR2, BARR2, beta-arrestin-2, arrestin 3, non-visual arrestin-3
- HostMouse
- Storage Instruction-20°C
- UNSPSC12352203